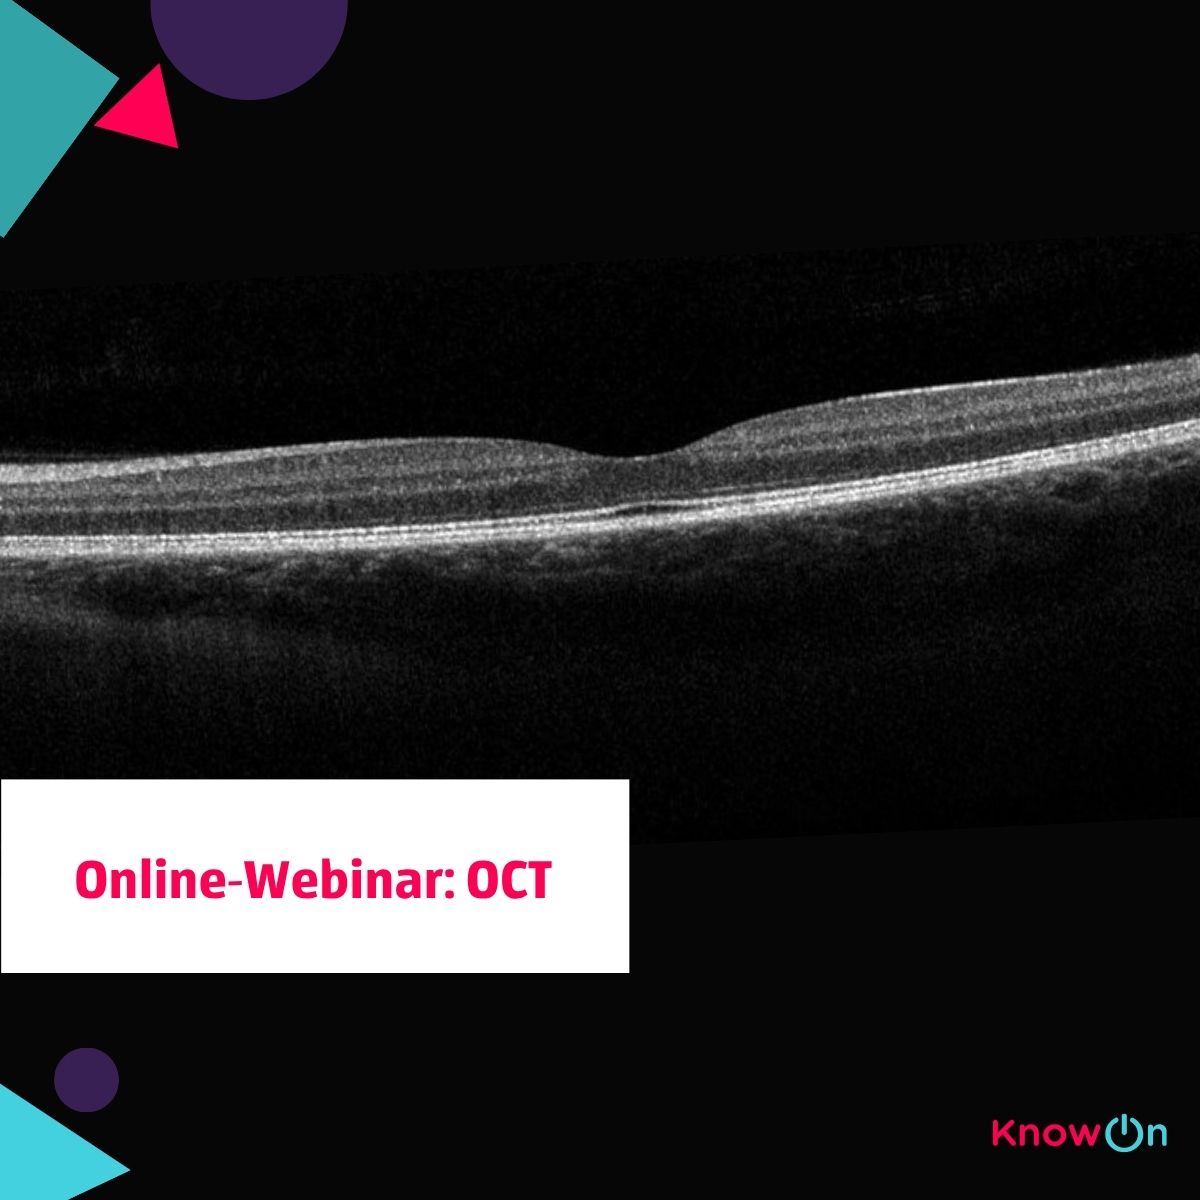

Webinar: Werde zum OCT-Experten
Exklusives Webinar für MFAs
Webinar: Werde zum OCT-Experten
Exklusives Webinar für MFAs
KnowOn GmbH
GF: Nadine Dyck
Simeonscarré 2
32423 Minden
+49 151 1768 0317

Willkommen zur ultimativen OCT-Meisterklasse, exklusiv für Ihre Augenarztpraxis! Mitunserem dynamischen Online-Kurs machen wir Ihre Mitarbeitenden auf allen Ebenen fit zum Thema optische Kohärenztomographie (OCT). Gemeinsam mit der erfahrenen Referentin Claudia Winner tauchen wir in die Welt der OCT ein und optimieren die Fähigkeiten Ihres Teams für präzisere Untersuchungen und fundierte Diagnosen.
-
Basisinformation
Datum20.11.2025, 18:30 - 19:30SpracheDeutschGebühren ab75.00 EURVeranstalterKnowOn GmbH
OrganisatorKnowOn GmbH
GF: Nadine Dyck
Simeonscarré 2
32423 Minden
+49 151 1768 0317
-
Programm
Inhalte:
- Unterschiede zwischen guten und schlechten Aufnahmen
- Praktische Tipps zur Verbesserung Ihrer OCT-Aufnahmen
- Interpretation von Bildern und Diagnosegrundlagen
- Richtige Zuordnung von rechtem und linkem Auge
- Häufige Befunde und ihre Hintergründe
- Zeit für Fragen und Antworten aus dem Praxisalltag
Jeder Teilnehmer erhält vorab ein eLearning, um das Basiswissen zu vertiefen. Das Webinar dauert ca. 60 Minuten und bietet eine wertvolle Möglichkeit, Ihr Fachwissen zu erweitern und Ihre Fähigkeiten zu verbessern.
Zur Referentin Claudia Winner:
Mit einem fundierten akademischen Hintergrund in der Augenoptik und über 15 Jahren Erfahrung in refraktiven operativen Zentren zählt Claudia Winner zu den versierten Expertinnen im Bereich der refraktiven Patientenberatung und Planung. Sie begleitet Patientinnen und Patienten mit hoher fachlicher Kompetenz und präziser Analyse durch den gesamten Entscheidungsprozess.- Duales Studium der Augenoptik
- Dipl.-Ing. Augenoptik (FH)
- Seit 15 Jahren Refraktivmanagerin in operativen Zentren
- Freiberufliche Spezialistin für die Berechnung von Premium-Intraokularlinsen
-
Gebühren
alleGebühren ab75,00 EURPro Teilnehmendem und inkl. MwSt.
-
Buchung / Anmeldung
Hier geht es zur Online-Buchung.
-
Zertifizierung
Keine Zertifizierung beantragt